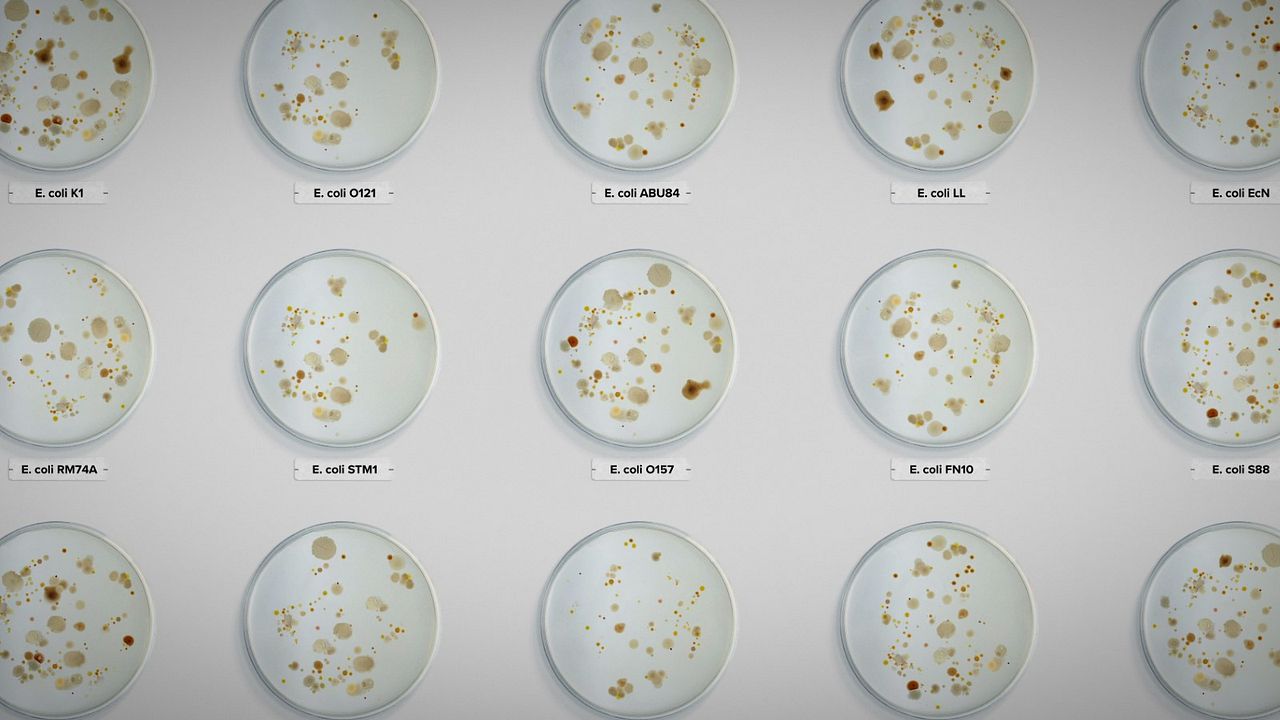
Intoxicación: La cruda verdad sobre nuestra comida : Foto

8 / 18 Fotos
Intoxicación: La cruda verdad sobre nuestra comida : Foto
Foto añadida el 7 de agosto de 2023
|Copyright Netflix